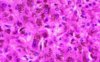

Histo: Liver Flashcards
(43 cards)
What is the average weight of a liver?
1500 g
Describe the blood supply to the liver.
Dual blood supply: hepatic artery and hepatic portal vein
NOTE: this means that the liver does not tend to get affected by ischaemia
List the main cell types of the liver.
- Hepatocytes
- Bile ducts (cholangiocytes)
- Blood vessels
- Endothelial cells
- Kupffer cells
- Stellate cells
How is the arrangement of endothelial cells in the liver different from other parts of the body?
The endothelial cells do not sit on a basement membrane and the endothelium is discontinuous (there are no tight junctions)
What is the role of stellate cells and what could happen to them when activated?
- Storage of vitamin A
- When activated, they become myofibroblasts that lay down collagen (this is responsible for scarring in liver disease)
outline the arrangement of structures within a normal liver.
- There will be portal tracts consisting of a branch of the hepatic artery, a branch of the portal vein and a bile duct
- Blood will flow from the portal tract to the central vein
- There is a ring of collagen around the portal tract called the limiting plate
- There are three zones of hepatocytes in between the portal tract and the central vein
- Zone 3 is closest to the central vein and contains the most metabolically active enzymes

Describe the arrangement of hepatocytes, endothelial cells, stellate cells and Kupffer cells in a normal liver.
- There are spaces in between endothelial cells and there is a gap in between the endothelial cells and the hepatocytes (space of Disse)
- Stellate cells sit within the space of Disse
- Kupffer cells are found within the sinusoids
- Blood can easily get through the spaces in the endothelial cells in the space of Disse where they are exposed to hepatocytes

Describe how cell arrangements change in liver disease.
- Kupffer cells become activated (inflammatory response)
- Endothelial cells stick together so blood finds it more difficult to get into the space of Disse
- Stellate cells become activated and secrete basement membrane-type collagens into the space of Disse
- Hepatocytes lose their microvilli
- All these changes make it difficult for blood to be exposed to hepatocytes

What are the key features of cirrhosis?
- The whole liver is involved
- There is extensive fibrosis and nodules of regenerating hepatocytes
- Distortion of liver vascular architecture: intra- and extra-hepatic shunting of blood
Name and describe the two types of shunting that occur in cirrhosis.
- Extra-hepatic: blood never reaches the liver because it backlogs into sites of porto-systemic anastamosis
- Intra-hepatic: blood goes through the liver but it does not come into contact with hepatocytes (so the blood is unfiltered)

How can cirrhosis be classified?
- According to nodule size (old system): micro- or macronodular
- According to aetiology: alcohol/insulin resistance or viral hepatitis
How do these two classications of cirrhosis overlap?
Alcoholic tends to be micronodular
Viral tends to be macronodular
List some complications of cirrhosis.
- Portal hypertension
- Hepatic encephalopathy
- Hepatocellular carcinoma
NOTE: cirrhosis may be reversible
What causes acute hepatitis?
- Hepatitis virus (A and E)
- drugs
What is a common histological feature of all acute hepatitis?
Spotty necrosis

What are some causes of chronic hepatitis?
- Viral hepatitis
- Drugs
- Autoimmune
How can the histology in chronic hepatitis be used to grade and stage the disease?
- Severty of inflammation = grade (how bad does it look)
- Severity of fibrosis = stage (how far has it spread)
What is interface hepatitis?
- Aka piecemeal hepatitis
- Inflammation crosses the limiting plate making it difficult to distinguish where the portal tract ends and the hepatocytes begin

What are the three histological patterns of alcoholic liver disease?
- Fatty liver
- Alcoholic hepatitis
- Cirrhosis
NOTE: these may co-exist (they are not distinc entities)
List some histological features of alcoholic hepatitis.
- Ballooning - cell swell and may contain pink depositis within cells (Mallory Denk bodies/Mallory hyaline)
- Apoptosis
- Pericellular fibrosis (chicken wire fibrosis)

In which part of the liver do the histological features of alcoholic hepatitis tend to be seen and why?
- Zone 3
- Alcohol is not toxic, but acetaldehyde is toxic
- Zone 3 cells contain the most alcohol dehydrogenase thereby producing the most acetaldehyde
- Furthermore, by the time blood reaches zone 3 (after passing zones 1 and 2) it is relatively hypoxic making the cells in zone 3 even more vulnerable to damage
Describe the histological appearance of non-alcoholic fatty liver disease.
- Looks like alcoholic hepatitis
NOTE: caused by insulin resistance associated with a raised BMI and diabetes
How is NAFLD distinguished from alcoholic lver disease?
Based on the history
AST:ALT ratio <2 in NAFLD
What is primary biliary cholangitis?
Autoimmune conditions characterised by bile duct loss associated with chronic inflammation (with granulomas)